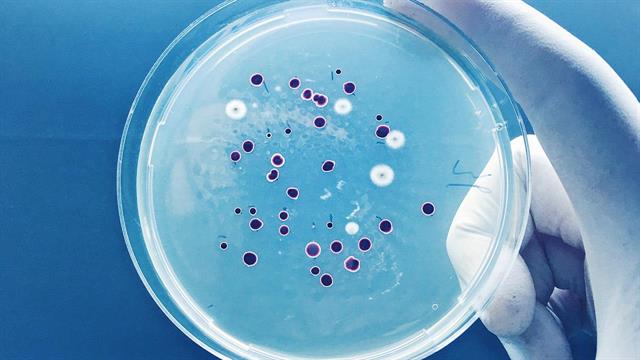
ECDC - EFSA: Ρουτίνα η ανακάλυψη ανθεκτικών στα αντιβιοτικά βακτηρίων σε ανθρώπους και ζώα

Πρόσφατα δεδομένα επιτήρησης αποκαλύπτουν ότι η αντοχή στα κοινώς χρησιμοποιούμενα αντιμικροβιακά - όπως η αμπικιλλίνη, οι τετρακυκλίνες και οι σουλφοναμίδες - παραμένει επίμονα υψηλή τόσο στον άνθρωπο όσο και στα ζώα για βασικά παθογόνα, όπως η Salmonella και το Campylobacter.
Τον κώδωνα του κινδύνου κρούουν επιστήμονες του Ευρωπαϊκού Κέντρου Ελέγχου Νοσημάτων (ECDC) και της Ευρωπαϊκής Αρχής για την Ασφάλεια των Τροφίμων (EFSA) σε έκθεση, η οποία δημοσιεύτηκε σήμερα.
Όπως αναφέρουν, αντίσταση στο κολκοβακτηρίδιο E. coli παρατηρείται επίσης συχνά σε ζώα, αν και η αντοχή της σαλμονέλας στις ωοτόκες όρνιθες είναι χαμηλή.
Σύμφωνα με τον Carlos Das Neves, επικεφαλής επιστήμονα της EFSA και τον Piotr Kramarz, επικεφαλής επιστήμονα του ECDC: "Μια ολοκληρωμένη προσέγγιση One-Health είναι απαραίτητη για την αντιμετώπιση της μικροβιακής αντοχής. Ισχυρά συστήματα επιτήρησης, συνετή αντιμικροβιακή χρήση και διατομεακή συνεργασία είναι ζωτικής σημασίας για τον μετριασμό του κινδύνου από ανθεκτικά στα αντιβιοτικά βακτήρια που μπορούν να εξαπλωθούν μεταξύ ζώων και ανθρώπων".
Η υψηλή αντοχή στη σιπροφλοξασίνη, ένα εξαιρετικά σημαντικό αντιμικροβιακό φθοριοκινολόνης για τη θεραπεία των λοιμώξεων από Salmonella και Campylobacter, είναι μια αυξανόμενη ανησυχία. Η αντοχή στη σιπροφλοξασίνη βρέθηκε να αυξάνεται στη Salmonella Enteritidis και στο Campylobacter jejuni από ανθρώπους σε περισσότερες από τις μισές ευρωπαϊκές χώρες που υπέβαλαν δεδομένα.
Υψηλά έως εξαιρετικά υψηλά ποσοστά αντοχής στη σιπροφλοξασίνη έχουν παρατηρηθεί στο Campylobacter από ζώα που παράγουν τρόφιμα και ειδικά στη Salmonella και το E. coli από πουλερικά. Αυτές οι τάσεις είναι ιδιαίτερα ανησυχητικές καθώς η λίστα επιβλαβών βακτηρίων του Παγκόσμιου Οργανισμού Υγείας για το 2024 κατατάσσει την ανθεκτική στη φθοροκινολόνη μη τυφοειδή σαλμονέλα (ορότυποι σαλμονέλας που δεν προκαλούν τυφοειδή πυρετό) ως υψηλή προτεραιότητα.
Αντίθετα, η αντοχή σε άλλα κρίσιμα σημαντικά αντιμικροβιακά που χρησιμοποιούνται στην ανθρώπινη ιατρική παραμένει ασυνήθιστη για τη Salmonella και το Campylobacter, τόσο για τον άνθρωπο όσο και για τα ζώα που παράγουν τρόφιμα.
Αν και η αντοχή στην καρβαπενέμη παραμένει σπάνια, η περιστασιακή ανίχνευση ανθεκτικού στην καρβαπενέμη E. coli σε τρόφιμα και ζώα απαιτεί συνεχή επαγρύπνηση και περαιτέρω επιδημιολογικές έρευνες. Αυτό είναι ιδιαίτερα σημαντικό επειδή τα ανθεκτικά στην καρβαπενέμη βακτήρια Enterobacterales αναγνωρίζονται ως κρίσιμη απειλή για τη δημόσια υγεία. Για να υποστηρίξει αυτή την προσπάθεια, το 2025 η EFSA θα δημοσιεύσει την πρώτη από μια σειρά γνωμοδοτήσεων σχετικά με την τρέχουσα κατάσταση της εμφάνισης και εξάπλωσης των εντεροβακτηριδίων που παράγουν καρβαπενεμάση στην τροφική αλυσίδα στην Ευρωπαϊκή Ένωση/Ευρωπαϊκό Οικονομικό Χώρο και στην Ελβετία.
Μείωση αντοχής
Ωστόσο, υπάρχουν και θετικές τάσεις, με τα στοιχεία να αποκαλύπτουν σημαντική πρόοδο στη μείωση των επιπέδων αντίστασης σε αρκετές χώρες που αναφέρουν. Σχεδόν οι μισές ευρωπαϊκές χώρες που υπέβαλαν δεδομένα έδειξαν μείωση της αντοχής του Campylobacter στα μακρολιδικά αντιβιοτικά, τόσο στο C. jejuni όσο και στο C. coli, σε ανθρώπινες περιπτώσεις.
Επιπλέον, η αντοχή των απομονωθέντων στελεχών Salmonella Typhimurium από τον άνθρωπο στις πενικιλίνες και τις τετρακυκλίνες έχει μειωθεί με την πάροδο του χρόνου.
Οι σημαντικές αυξητικές τάσεις στον βασικό δείκτη έκβασης για την πλήρη ευαισθησία του E. coli, καθώς και οι σημαντικές φθίνουσες τάσεις στον βασικό δείκτη έκβασης για τον επιπολασμό του E. coli που παράγει ESBL-/AmpC δείχνουν ότι έχει σημειωθεί ενθαρρυντική πρόοδος στη μείωση της AMR σε ζώα παραγωγής τροφίμων σε αρκετά κράτη μέλη της ΕΕ τα τελευταία χρόνια.
Παρά ορισμένες βελτιώσεις, η μικροβιακή αντοχή παραμένει μια σημαντική απειλή για τη δημόσια υγεία που απαιτεί συντονισμένη δράση με μια προσέγγιση One-Health.
Τα βασικά μέτρα περιλαμβάνουν την προώθηση της υπεύθυνης χρήσης αντιμικροβιακών, τη βελτίωση της πρόληψης και του ελέγχου των λοιμώξεων, την επένδυση στην έρευνα για νέες θεραπείες και την εφαρμογή ισχυρών εθνικών πολιτικών για την αποτελεσματική καταπολέμηση της αντοχής.
Προσθέστε το iatronet.gr στο Discover
Ειδήσεις υγείας σήμερα
Ποιες τροφές καταπολεμούν το στρες
Η Κύμη τίμησε την παρακαταθήκη του Γεωργίου Παπανικολάου με μια εκδήλωση για την υγεία
Οι υπερεπεξεργασμένες τροφές συνδέονται με διαφορές στον εγκέφαλο παιδιών [μελέτη]
Το 45% των Ελλήνων καταναλώνουν μία συσκευασία αντιβιοτικών ετησίως - Οι περιοχές που είναι στο κόκκινο [πίνακες]
Το 45% των Ελλήνων καταναλώνουν μία συσκευασία αντιβιοτικών ετησίως - Οι περιοχές που είναι στο κόκκινο [πίνακες] Διάσκεψη κατά της ανθεκτικής στα αντιβιοτικά φυματίωσης στην Ευρώπη
Διάσκεψη κατά της ανθεκτικής στα αντιβιοτικά φυματίωσης στην Ευρώπη Πιο αποτελεσματική η αντιμετώπιση των ανθεκτικών μικροβίων με τη σωστή σειρά των αντιβιοτικών
Πιο αποτελεσματική η αντιμετώπιση των ανθεκτικών μικροβίων με τη σωστή σειρά των αντιβιοτικών Επιστήμονες σχεδιάζουν αντιβιοτικά στο εργαστήριο με τη βοήθεια τεχνητής νοημοσύνης
Επιστήμονες σχεδιάζουν αντιβιοτικά στο εργαστήριο με τη βοήθεια τεχνητής νοημοσύνης Ανάκληση παρτίδας αντιβιοτικού από τον ΕΟΦ
Ανάκληση παρτίδας αντιβιοτικού από τον ΕΟΦ Τα αντιβιοτικά επηρεάζουν το εντερικό μικροβίωμα για αρκετά χρόνια [μελέτη]
Τα αντιβιοτικά επηρεάζουν το εντερικό μικροβίωμα για αρκετά χρόνια [μελέτη] Ποιες τροφές καταπολεμούν το στρες
Ποιες τροφές καταπολεμούν το στρες Ψυχοθεραπεία μέσω εικονικής πραγματικότητας - Πώς εφαρμόζεται
Ψυχοθεραπεία μέσω εικονικής πραγματικότητας - Πώς εφαρμόζεται Καλοκαίρι και θηλασμός: Στις διακοπές γίνεται ακόμη πιο πολύτιμος
Καλοκαίρι και θηλασμός: Στις διακοπές γίνεται ακόμη πιο πολύτιμος "Προλαμβάνω" - Παχυσαρκία: Προβλήματα σε ασθενείς από την ολοκλήρωση του προγράμματος
"Προλαμβάνω" - Παχυσαρκία: Προβλήματα σε ασθενείς από την ολοκλήρωση του προγράμματος Στατίνες: Προκαλούν σοβαρά μυϊκά προβλήματα;
Στατίνες: Προκαλούν σοβαρά μυϊκά προβλήματα; Τι ζητούν οι Τεχνολόγοι Ιατρικών Εργαστηρίων
Τι ζητούν οι Τεχνολόγοι Ιατρικών Εργαστηρίων Ανακαλείται επιδόρπιο γάλακτος πουτίγκας με γεύση σοκολάτα
Ανακαλείται επιδόρπιο γάλακτος πουτίγκας με γεύση σοκολάτα Ιδέες για πρωινό με πολλή πρωτεΐνη
Ιδέες για πρωινό με πολλή πρωτεΐνη Ρύζι, πατάτες και ζυμαρικά: Ποιο είναι χειρότερο για το σάκχαρο;
Ρύζι, πατάτες και ζυμαρικά: Ποιο είναι χειρότερο για το σάκχαρο; Aνατροπή της τελευταίας στιγμής
Aνατροπή της τελευταίας στιγμής Pfizer: Νέα ιατρική διευθύντρια η Χριστίνα Μιχαηλίδη
Pfizer: Νέα ιατρική διευθύντρια η Χριστίνα Μιχαηλίδη Τι πιστεύουν οι υγειονομικοί για τον αντιγριπικό εμβολιασμό [έρευνα]
Τι πιστεύουν οι υγειονομικοί για τον αντιγριπικό εμβολιασμό [έρευνα]